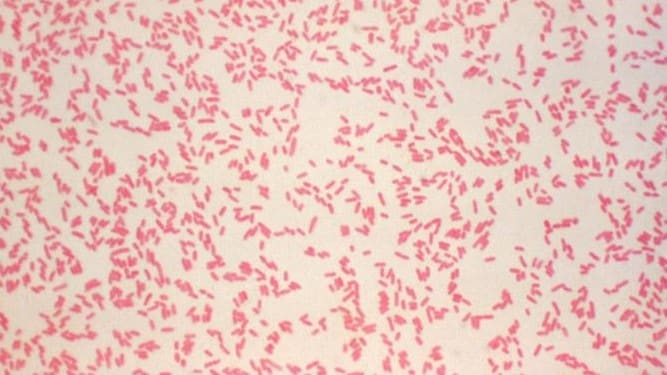
Photomicrograph showing a field of numerous Gram-negative, rod-shaped Yersinia enterocolitica bacteria.

What to know
- CDC recommends use cefsulodin-irgasan-novobiocin (CIN) agar for isolation of Yersinia ssp. from non-sterile sites.
- Tests should be performed on a pure culture for complete identification.
Guidance
CDC recommends the use of cefsulodin-irgasan-novobiocin (CIN) agar for isolation of Yersinia spp. from nonsterile sites.
Incubation at 25°C is recommended to prevent loss of the virulence plasmid in Y. enterocolitica. The lower temperature promote growth of Yersinia over some other members of the Enterobacteriaceae family that can grow on CIN agar.
Biochemical or molecular tests should be performed on a pure culture for complete identification.

Types of tests
Culture-independent diagnostic tests
Several culture-independent diagnostic tests (CIDTs) are now available and have more than doubled the detection rate of Yersinia spp. in the United States.
CIDT panels typically target only Y. enterocolitica, and the rarity of yersiniosis has precluded robust evaluation of the specificity and sensitivity of CIDT platforms through prospective studies.
Culture tests
Culture is required to determine the species and for antimicrobial susceptibility testing.
Submitting specimens
Contact your local or state health department for information about diagnostic testing beyond the capacity of the clinical laboratory.
Public health officials can provide information and guidance on specimen submission, including to CDC, if appropriate. Learn more >
